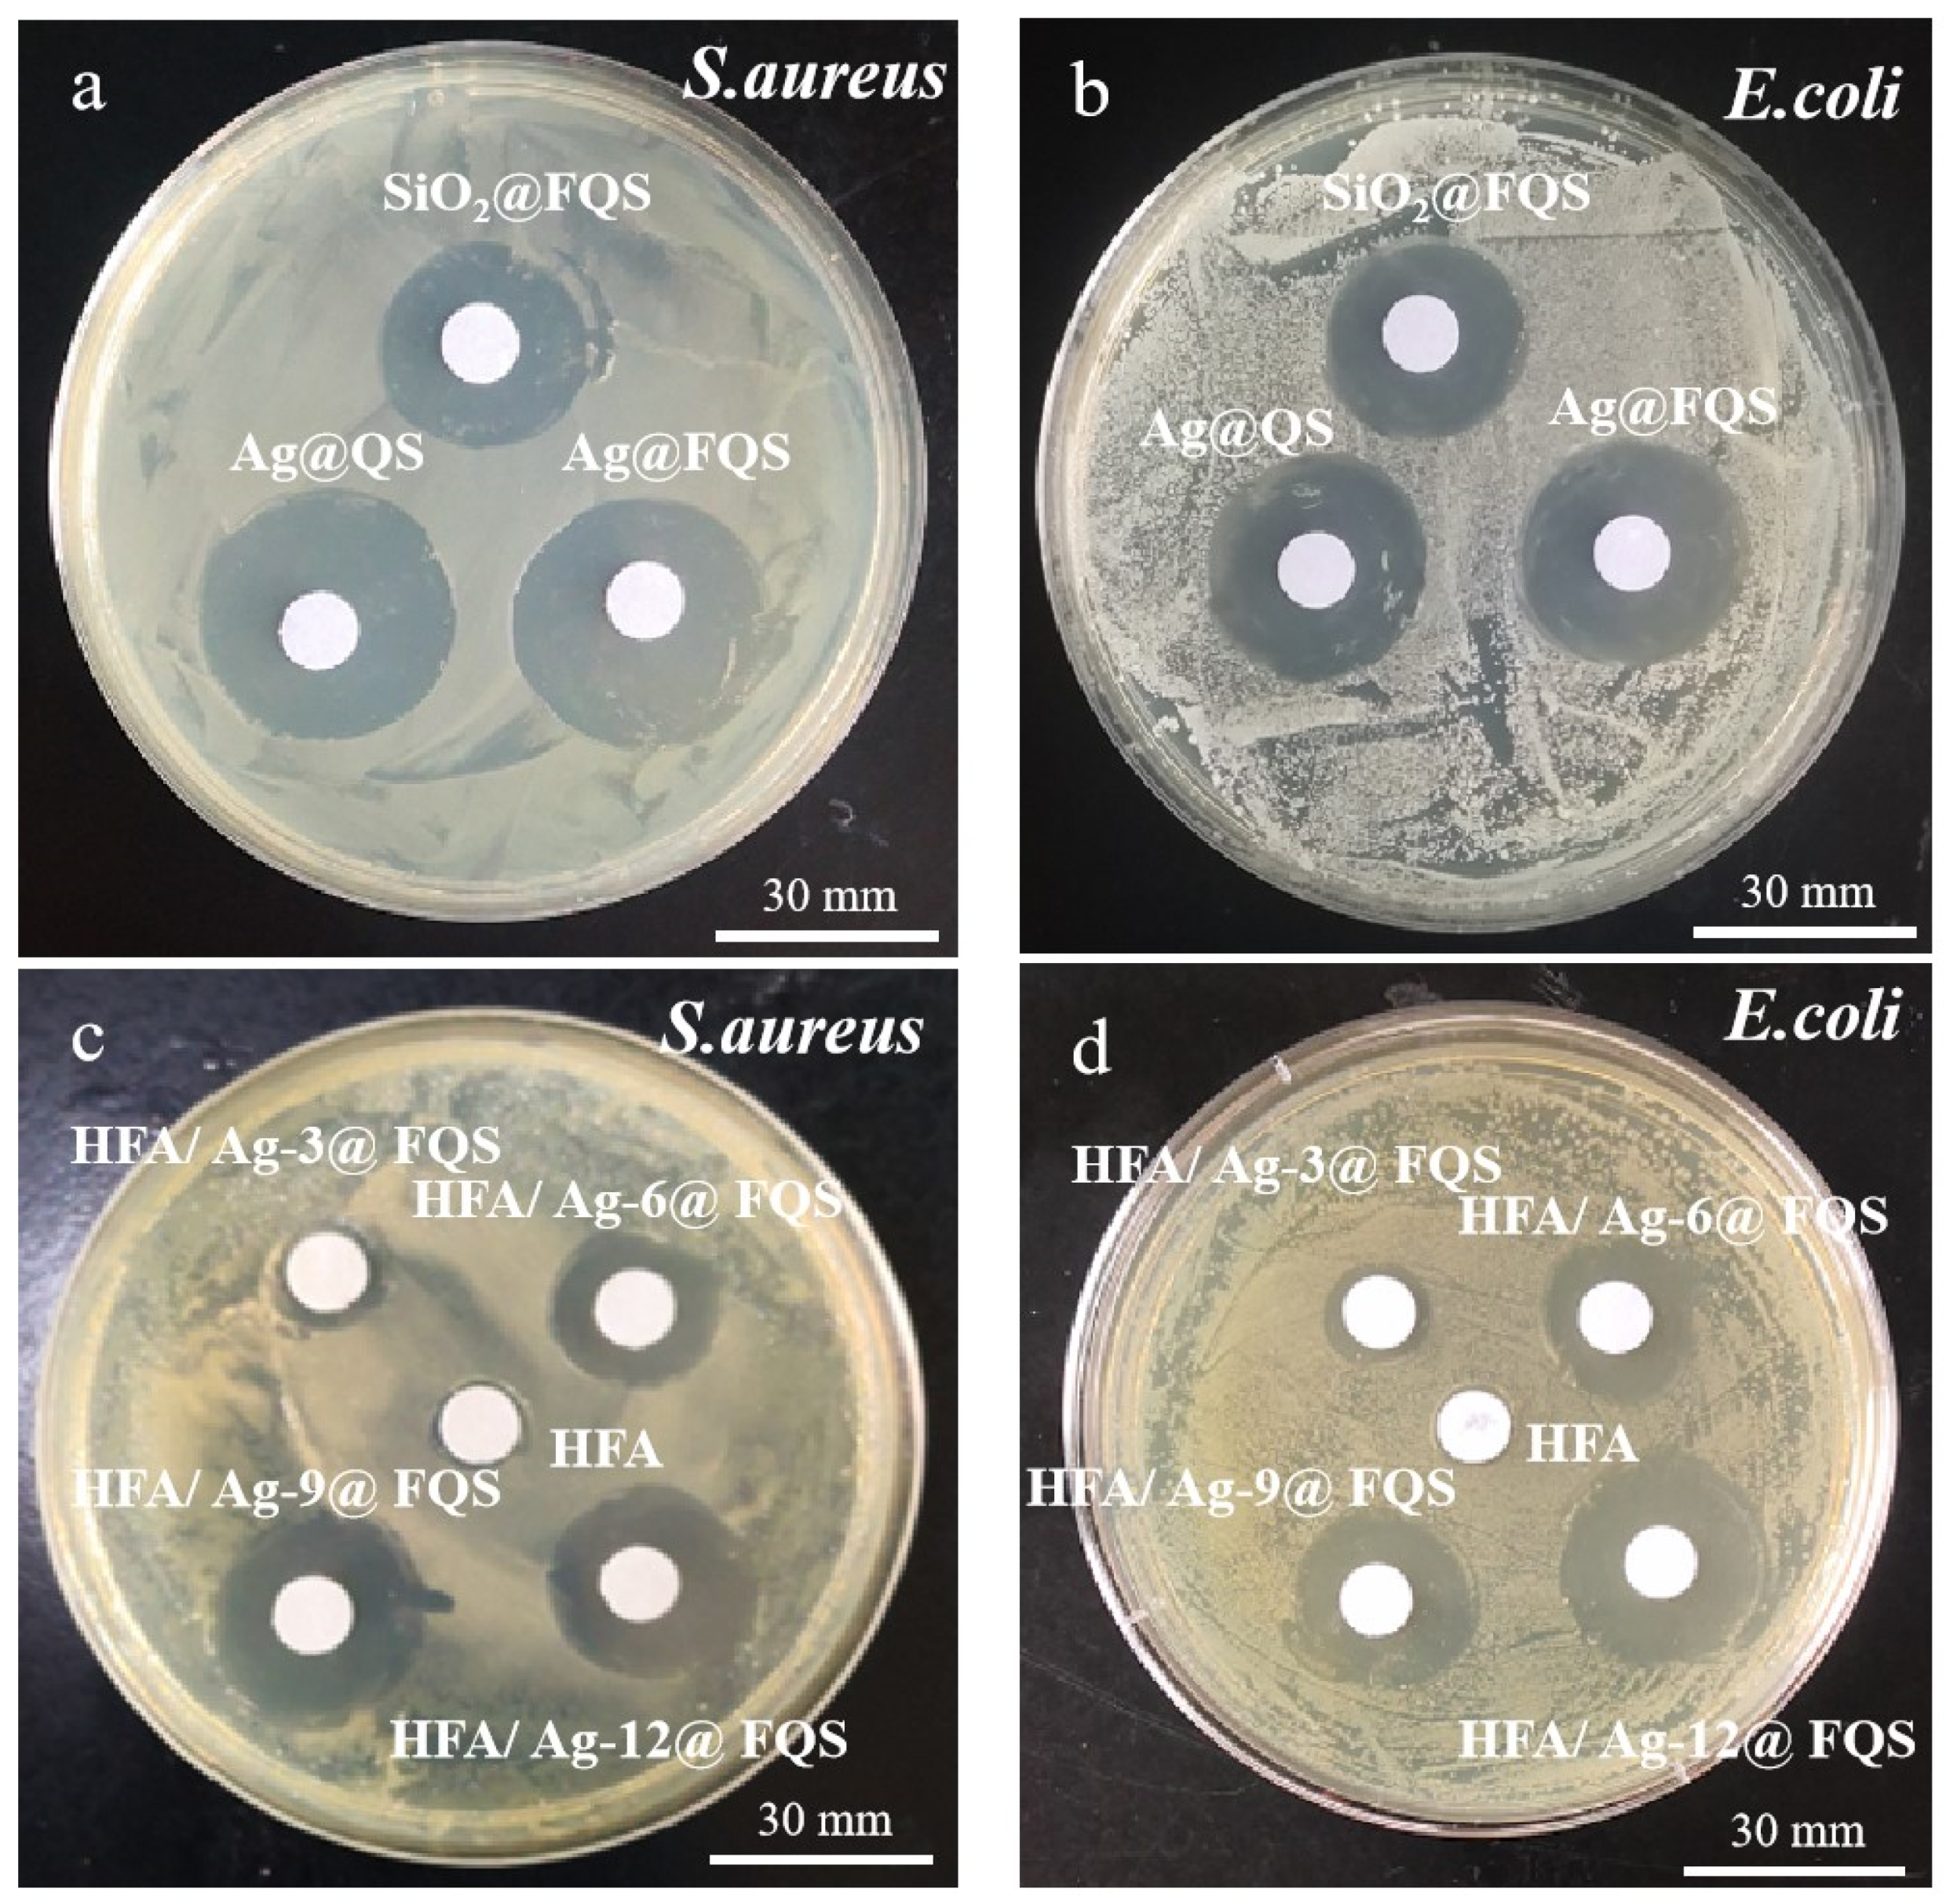
Polymers 16 01885 g011

Self-Cleaning Antibacterial Composite Coating of Fluorinated Acrylic Resin and Ag/SiO2 Nanoparticles with Quaternary Ammonium
Abstract
1. Introduction
2. Experimental
2.1. Materials and Reagents
2.2. Synthesis of Hydrophobic Fluorinated Acrylic Resin
2.3. Preparation of Ag/SiO2 Nanoparticles with Fluorinated Chain and Quaternary Ammonium Salts
2.4. Preparation of Superhydrophobic Antibacterial Coating of HFA/Ag@FQS
2.5. Characterization
3. Results and Discussion
3.1. Chemical Composition and Morphologies of HFA/Ag@FQS
3.2. Surface Morphology and Wettability of HFA and HFA/Ag@FQS
3.3. Durability of HFA/Ag@FQS Composite Coating
3.4. Self-Cleaning Performance of HFA/Ag@FQS Coatings
4. Antibacterial Properties of HFA/Ag@FQS Composite Coatings
5. Conclusions
Author Contributions
Funding
Institutional Review Board Statement
Data Availability Statement
Acknowledgments
Conflicts of Interest
References
- Han, Y.; Zhao, W.; Zheng, Y.; Wang, H.; Sun, Y.; Zhang, Y.; Luo, J.; Zhang, H. Self-adhesive lubricated coating for enhanced bacterial resistance. Bioact. Mater. 2021, 6, 2535–2545. [Google Scholar] [CrossRef] [PubMed]
- Jeong, Y.; Lee, K. Repetitive bacterial disinfection of respirators by polydopamine coating. Appl. Sci. 2022, 12, 8710. [Google Scholar] [CrossRef]
- Sevencan, A.; Doyuk, E.K.; Köse, N. Silver ion doped hydroxyapatite-coated titanium pins prevent bacterial colonization. Jt. Dis. Relat. Surg. 2021, 32, 35–41. [Google Scholar] [CrossRef] [PubMed]
- Xi, W.; Hegde, V.; Zoller, S.D.; Park, H.Y.; Hart, C.M.; Kondo, T.; Hamad, C.D.; Hu, Y.; Loftin, A.H.; Johansen, D.O.; et al. Point-of-care antimicrobial coating protects orthopaedic implants from bacterial challenge. Nat. Commun. 2021, 12, 5473. [Google Scholar] [CrossRef] [PubMed]
- Uzoma, P.C.; Wang, Q.M.; Zhang, W.Y.; Gao, N.J.; Li, J.W.; Okonkwo, P.C.; Liu, F.C.; Han, E.H. Anti-bacterial, icephobic, and corrosion protection potentials of superhydrophobic nanodiamond composite coating. Colloid. Surface. Asp. 2021, 630, 127532–127537. [Google Scholar] [CrossRef]
- Al Rugaie, O.; Abdellatif, A.A.H.; El-Mokhtar, M.A.; Sabet, M.A.; Abdelfattah, A.; Alsharidah, M.; Aldubaib, M.; Barakat, H.; Abudoleh, S.M.; Al-Regaiey, K.A.; et al. Retardation of bacterial biofilm formation by coating urinary catheters with metal nanoparticle-stabilized polymers. Microorganisms 2022, 10, 1297. [Google Scholar] [CrossRef] [PubMed]
- Li, C.-B.; Wang, F.; Sun, R.-Y.; Nie, W.-C.; Song, F.; Wang, Y.-Z. A multifunctional coating towards superhydrophobicity, flame retardancy and antibacterial performances. Chem. Eng. J. 2022, 450, 138031. [Google Scholar] [CrossRef]
- Li, Y.; Li, H.; Wu, J.; Yang, X.Y.; Jia, X.H.; Yang, J.; Shao, D.; Feng, L.; Wang, S.Z.; Song, H.J. One-pot synthesis of superhydro-phobic photothermal materials with self-healing for efficient ice removal. Appl. Surf. Sci. 2022, 600, 154177. [Google Scholar] [CrossRef]
- Brassard, J.-D.; Sarkar, D.; Perron, J. Fluorine based superhydrophobic coatings. Appl. Sci. 2012, 2, 453–464. [Google Scholar] [CrossRef]
- Razavi, S.M.R.; Oh, J.; Haasch, R.T.; Kim, K.; Masoomi, M.; Bagheri, R.; Slauch, J.M.; Miljkovic, N. Environment-friendly antibiofouling superhydrophobic coatings. ACS Sustain. Chem. Eng. 2019, 7, 14509–14520. [Google Scholar] [CrossRef]
- Song, H.-J.; Zhang, Z.-Z.; Men, X.-H. Superhydrophobic PEEK/PTFE composite coating. Appl. Phys. A 2008, 91, 73–76. [Google Scholar] [CrossRef]
- Zhan, Y.; Yu, S.; Amirfazli, A.; Siddiqui, A.R.; Li, W. Recent Advances in antibacterial superhydrophobic coatings. Adv. Eng. Mater. 2022, 24, 2101053. [Google Scholar] [CrossRef]
- Basu, B.J.; Bharathidasan, T.; Anandan, C. Superhydrophobic oleophobic PDMS-silica nanocomposite coating. Surf. Innov. 2013, 1, 40–51. [Google Scholar] [CrossRef]
- Chen, Z.J.; Shen, B.B.; Zhang, Y.L.; Guo, H.L.; Zhong Chen, Z.; Wei, R.; Hu, J. Superhydrophobic coating of a modified calcium sulfate whiskers@SiO2-F/TPU for anti-icing applications. Adv. Powder Technol. 2024, 35, 104362–104369. [Google Scholar] [CrossRef]
- Wen, X.; Hong, C.; Li, H.; Xu, F.; Li, Y.; Sun, J. Supramolecular polymer-based, ultra-robust, and nonfluorinated, sub-zero temperature self-healing superhydrophobic coatings for energy harvesting. Nano Energy 2024, 125, 109561. [Google Scholar] [CrossRef]
- Nadaraia, K.; Suchkov, S.; Imshinetskiy, I.; Mashtalyar, D.; Kosianov, D.; Belov, E.; Sinebryukhov, S.; Gnedenkov, S. New superhydrophobic composite coatings on Mg-Mn-Ce magnesium alloy. J. Magnes. Alloy. 2023, 11, 1721–1739. [Google Scholar] [CrossRef]
- Assis, M.; Simoes, L.G.P.; Tremiliosi, G.C.; Ribeiro, L.K.; Coelho, D.; Minozzi, D.T.; Santos, R.I.; Vilela, D.C.B.; Mascaro, L.H.; Andrés, J.; et al. PVC-SiO2-Ag composite as a powerful biocide and anti-SARS-CoV-2 material. J. Polym. Res. 2021, 28, 361. [Google Scholar] [CrossRef]
- Marcelo, A.; Luiz, G.P.; Simoes, G.C.; Tremiliosi, G.C.; Minozzi, D.T.; Santos, R.I.; Vilela, D.C.B.; Santos, J.R.; Ribeiro, L.K.; Rosa, I.L.V.; et al. SiO2-Ag composite as a highly virucidal material: A roadmap that rapidly eliminates SARS-CoV-2. Nanomaterials 2021, 11, 638. [Google Scholar] [CrossRef] [PubMed]
- Kong, C.C.; Chen, S.; Ge, W.H.; Zhao, Y.; Xu, X.D.; Wang, S.M.; Zhang, J.F. Riclin-capped silver nanoparticles as an antibacte-rial and anti-inflammatory wound dressing. Int. J. Nanomed. 2022, 2022, 2629–2641. [Google Scholar] [CrossRef] [PubMed]
- Yang, J.; Chen, Y.; Jia, X.; Li, Y.; Wang, S.; Song, H. Wood-based Solar Interface Evaporation Device with self-desalting and high antibacterial activity for efficient solar steam generation. ACS Appl. Mater. Interfaces 2020, 12, 47029–47037. [Google Scholar] [CrossRef] [PubMed]
- Zhou, Z.; Zhou, S.; Zhang, X.; Zeng, S.; Xu, Y.; Nie, W.; Zhou, Y.; Xu, T.; Chen, P. Quaternary ammonium salts: Insights into synthesis and new directions in antibacterial applications. Bioconjugate Chem. 2023, 34, 302–325. [Google Scholar] [CrossRef] [PubMed]
- Wang, C.; Zhang, Q.X.; Hou, G.G.; Wang, C.H.; Yan, H.H. Sustained release of EGF/bFGF growth factors achieved by mus-sel-inspired core–shell nanofibers with hemostatic and anti-inflammatory effects for promoting wound healing. Eur. Polym. J. 2023, 190, 112003–112008. [Google Scholar] [CrossRef]
- An, L.L.; Heo, J.W.; Chen, J.S.; Kim, Y.S. Water-soluble lignin quaternary ammonium salt for electrospun morpholo-gy-controllable antibacterial polyvinyl alcohol/lignin quaternary ammonium salt nanofibers. J. Clean. Prod. 2022, 368, 133219–133223. [Google Scholar] [CrossRef]
- Liu, C.; Li, X.; Lin, Y.; Xue, X.; Yuan, Q.; Zhang, W.; Bao, Y.; Ma, J. Tribological properties of bismaleimide-based self-lubricating composite enhanced by MoS2 quantum dots/graphene hybrid. Compos. Commun. 2021, 28, 100922. [Google Scholar] [CrossRef]
- Zou, W.; Gu, J.; Li, J.; Wang, Y.; Chen, S. Tailorable antibacterial and cytotoxic chitosan derivatives by introducing quaternary ammonium salt and sulfobetaine. Int. J. Biol. Macromol. 2022, 218, 992–1001. [Google Scholar] [CrossRef] [PubMed]
- Naderizadeh, S.; Dante, S.; Picone, P.; Di Carlo, M.; Carzino, R.; Athanassiou, A.; Bayer, I.S. Bioresin-based superhydrophobic coatings with reduced bacterial adhesion. J. Colloid Interface Sci. 2020, 574, 20–32. [Google Scholar] [CrossRef] [PubMed]
- Zheng, H.; Li, Z.; Liu, L.; Meng, F.; Cui, Y.; Wang, F. Superhydrophobic composite coatings in bacterial culture media: Durable antibacterial activity and enhanced corrosion resistance. Compos. Commun. 2021, 27, 100857. [Google Scholar] [CrossRef]
- Calvo-Correas, T.; Ugarte, L.; Trzebiatowska, P.J.; Sanzberro, R.; Datta, J.; Corcuera, M.Á.; Eceiza, A. Thermoplastic polyure-thanes with glycolysate intermediates from polyurethane waste recycling. Polym. Degrad. Stabil. 2017, 144, 411–419. [Google Scholar] [CrossRef]
- Wang, X.; Xu, L.; Wang, H.; Li, X.; Zhang, Q.; Gu, Y. Core-shell fluorine-silicon modified polyacrylic coating for corrosion protection of 304 stainless steel substrate. Int. J. Electrochem. Sci. 2021, 16, 151047. [Google Scholar] [CrossRef]
- Ponnupandian, S.; Chakrabarty, A.; Mondal, P.; Hoogenboom, R.; Lowe, A.B.; Singha, N.K. POSS and fluorine containing nanostructured block copolymer; Synthesis via RAFT polymerization and its application as hydrophobic coating material. Eur. Polym. J. 2020, 131, 109679. [Google Scholar] [CrossRef]
- Liu, H.Y.; Guo, C.X.; Cui, Y.N.; Yin, J.M.; Li, S.M. Experimental and modeling investigation of organic modified montmorillo-nite with octyl quaternary ammonium salt. Sci. Rep. 2022, 12, 14305. [Google Scholar] [CrossRef] [PubMed]
- An, Q.F.; Lyu, Z.J.; Shangguan, W.C.; Qiao, B.L.; Qin, P.W. The synthesis and morphology of a perfluoroalkyl oligosiloxane@SiO2 resin and its performance in antifingerprint coating. Coatings 2018, 8, 100. [Google Scholar] [CrossRef]
- Sezer, U.A.; Kocer, Z.; Sahin, I.; Aru, B.; Demirel, G.Y.; Sezer, S. Oxidized regenerated cellulose cross-linked gelatin microparticles for rapid and biocompatible hemostasis: A versatile cross-linking agent. Carbohydr. Polym. 2018, 200, 624–632. [Google Scholar] [CrossRef] [PubMed]
- Liu, Y.; Fan, L.; Xu, X.Z.; Mo, S.; Peng, D.; Mu, Q.H.; Zhu, C.Z.; Li, C.H.; Xu, J. Melt fluidity and thermal property of thermo-setting siloxane-containing polyimide resins and their organic/inorganic hybrid characteristics. Mater. Today Commun. 2020, 25, 101443. [Google Scholar] [CrossRef]
- An, Q.; Wang, K.; Jia, Y. Film morphology, orientation and performance of dodecyl/carboxyl functional polysiloxane on cotton substrates. Appl. Surf. Sci. 2011, 257, 4569–4574. [Google Scholar] [CrossRef]
- Liu, T.; Tang, H.; Cai, X.M.; Zhao, J.; Li, D.J.; Li, R.; Sun, X.L. A study on bactericidal properties of Ag coated carbon nanotubes. Nucl. Instrum. Methods Phys. Res. Sect. B Beam Interact. Mater. At. 2007, 264, 282–286. [Google Scholar] [CrossRef]
- Xing, H.; Cheng, J.; Tan, X.; Zhou, C.; Fang, L.; Lin, J. Ag nanoparticles-coated cotton fabric for durable antibacterial activity: Derived from phytic acid–Ag complex. J. Text. Inst. 2019, 111, 855–861. [Google Scholar] [CrossRef]
- Yan, Y.; Kang, S.-Z.; Mu, J. Preparation of high quality Ag film from Ag nanoparticles. Appl. Surf. Sci. 2007, 253, 4677–4679. [Google Scholar] [CrossRef]
- Zhang, D.; Liu, Y.F.; Shi, Y.H.; Huang, G.S. Effect of polyhedral oligomeric silsesquioxane (POSS) on crystallization behaviors of POSS/polydimethylsiloxane rubber nanocomposites. RSC Adv. 2014, 4, 6275–6283. [Google Scholar] [CrossRef]
- Boullanger, A.; Gracy, G.; Bibent, N.; Devautour-Vinot, S.; Clément, S.; Mehdi, A. From an octakis(3-cyanopropyl)silsesquioxane building block to a highly COOH-functionalized hybrid organic–inorganic material. Eur. J. Inorg. Chem. 2011, 2012, 143–150. [Google Scholar] [CrossRef]
- Wang, D.; Huang, J.; Guo, Z.; Liu, W. Durable mixed edible wax coating with stretching superhydrophobicity. J. Mater. Chem. A 2021, 9, 1495–1499. [Google Scholar] [CrossRef]
- Jing, X.; Guo, Z. Biomimetic super durable and stable surfaces with superhydrophobicity. J. Mater. Chem. A 2018, 6, 16731–16768. [Google Scholar] [CrossRef]
- Yassin, M.A.; Elkhooly, T.A.; Elsherbiny, S.M.; Reicha, F.M.; Shokeir, A.A. Facile coating of urinary catheter with Bio-inspired antibacterial coating. Heliyon 2019, 5, e02986. [Google Scholar] [CrossRef] [PubMed]
- Li, M.; Schlaich, C.; Kulka, M.W.; Donskyi, I.S.; Schwerdtle, T.; Unger, W.E.S.; Haag, R. Mussel-inspired coatings with tunable wettability, for enhanced antibacterial efficiency and reduced bacterial adhesion. J. Mater. Chem. B 2019, 7, 3438–3445. [Google Scholar] [CrossRef]
- Li, Y.; Li, H.; Wu, J.; Jia, X.; Zhang, Z.; Yang, J.; Miao, X.; Feng, L.; Song, H. Facile recycling of waste fabrics for preparing multifunctional photothermal protective materials. ACS Sustain. Chem. Eng. 2023, 11, 10566–10577. [Google Scholar] [CrossRef]
- Mei, L.; Lu, Z.; Zhang, X.; Li, C.; Jia, Y. Polymer-Ag nanocomposites with enhanced antimicrobial activity against bacterial infection. ACS Appl. Mater. Interfaces 2014, 6, 15813–15821. [Google Scholar] [CrossRef] [PubMed]
- Ghezzi, D.; Boi, M.; Sassoni, E.; Valle, F.; Giusto, E.; Boanini, E.; Baldini, N.; Cappelletti, M.; Graziani, G. Customized biofilm de-vice for antibiofilm and antibacterial screening of newly developed nanostructured silver and Zinc coatings. J. Biol. Eng. 2023, 17, 18. [Google Scholar] [CrossRef] [PubMed]

Disclaimer/Publisher’s Note: The statements, opinions and data contained in all publications are solely those of the individual author(s) and contributor(s) and not of MDPI and/or the editor(s). MDPI and/or the editor(s) disclaim responsibility for any injury to people or property resulting from any ideas, methods, instructions or products referred to in the content. |
© 2024 by the authors. Licensee MDPI, Basel, Switzerland. This article is an open access article distributed under the terms and conditions of the Creative Commons Attribution (CC BY) license (https://creativecommons.org/licenses/by/4.0/).
Share and Cite
Gu, J.; An, Q.; Huang, M.-c.; Ge, P.; Xue, C.-h. Self-Cleaning Antibacterial Composite Coating of Fluorinated Acrylic Resin and Ag/SiO2 Nanoparticles with Quaternary Ammonium. Polymers 2024, 16, 1885. https://doi.org/10.3390/polym16131885
Gu J, An Q, Huang M-c, Ge P, Xue C-h. Self-Cleaning Antibacterial Composite Coating of Fluorinated Acrylic Resin and Ag/SiO2 Nanoparticles with Quaternary Ammonium. Polymers. 2024; 16(13):1885. https://doi.org/10.3390/polym16131885
Chicago/Turabian StyleGu, Jiangdong, Qiufeng An, Meng-chen Huang, Ping Ge, and Chao-hua Xue. 2024. "Self-Cleaning Antibacterial Composite Coating of Fluorinated Acrylic Resin and Ag/SiO2 Nanoparticles with Quaternary Ammonium" Polymers 16, no. 13: 1885. https://doi.org/10.3390/polym16131885
APA StyleGu, J., An, Q., Huang, M.-c., Ge, P., & Xue, C.-h. (2024). Self-Cleaning Antibacterial Composite Coating of Fluorinated Acrylic Resin and Ag/SiO2 Nanoparticles with Quaternary Ammonium. Polymers, 16(13), 1885. https://doi.org/10.3390/polym16131885





